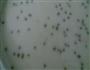
绿豆椰汁西米露的做法图解5

| 绿豆椰汁西米露热量分析 (可根据实际输入食材份量计算。数据仅供参考) | |||||
|---|---|---|---|---|---|
| 食材名称 | 食材份量 | 热量 | 标准度量(每100克) | 蛋白质 | 脂肪 |
| 绿豆 | 克 | 530千卡 | 329千卡 | 21.6克 | 0.8克 |
| 西米 | 克 | 250千卡 | 195千卡 | 12.4克 | 2.2克 |
| 总量 | 289克 | 绿豆椰汁西米露热量/卡路里780千卡 | |||

1/7. 把浸好的绿豆煲出沙,煲好先放在一边。

2/7. 西米要在开水后,才能下。

3/7. 把西米煲15左右,打开看看,如果西米中间有一点白色。就要关火闷20分钟。

4/7. 把闷煲好的西米,用冷水冲洗一遍。
5/7. 把椰浆和炼奶放到煲好的绿豆,放入冰糖。

6/7. 待冰糖煮融后,放入西米。然后把西米煮开和煮散就可以了。

7/7. 放入冰箱更好吃。
绿豆的热量329千卡(每100克);有利含量:低胆固醇,低钠盐,低饱和脂肪酸,富含维生素E,富含维生素B1,富含磷,富含钾,富含铁,富含蛋白质,富含膳食纤维;具有清热解毒、降血脂、抑制荨麻疹等功效;可与百合、黑米、马齿苋搭配;与鱼头、番茄、紫米相克,同食可能会引起不适;
西米的热量195千卡(每100克);有利含量:低胆固醇,低钠盐,低饱和脂肪酸,富含蛋白质;具有补肺、化痰、健脾等功效;